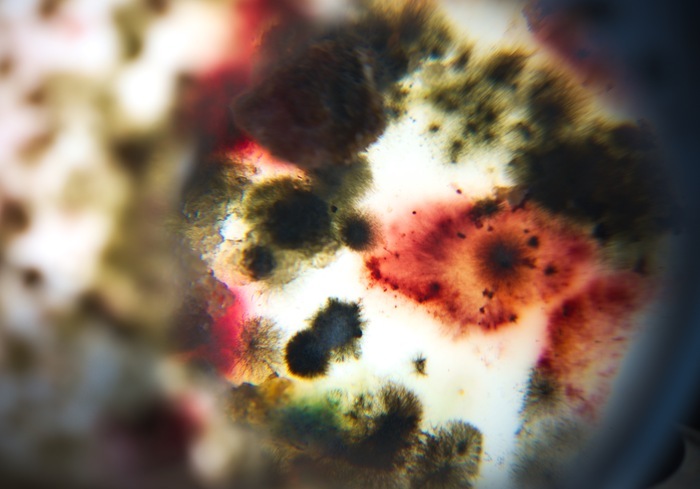
Pister l'invisible Théâtre Francine Vasse

Pister l’invisible Théâtre Francine Vasse Nantes
Pister l’invisible Théâtre Francine Vasse Nantes jeudi 12 mars 2026.
Date et horaire de début et de fin : 2026-03-12 19:00 – 20:00
Gratuit : non gratuit, réservation conseillée
Pister l’invisible est une exploration menée envers les vivants invisibles qui peuplent nos corps et qui nous entourent. Il semble que nous sommes en vérité, des foules tremblantes et grouillantes. Voici l’histoire d’une quête curieuse, parfois loufoque, envers ce que l’on ne voit pas, qui existe pourtant, dans laquelle chercheur.es et étudiant.es de Nantes Université ont embarqué. Travaux pratiques de microbiologie, récolte d’auto-portraits microbiens, entretiens avec des chercheur·es de différents horizons et expérimentations esthétiques variées furent autant de pas aventureux vers celles·ux qui nous habitent.Il est l’heure de raconter joyeusement le chemin parcouru à travers une performance mêlant paroles glanées dans les labos, expérimentations filmiques laborantines, danse et improvisations musicales pour microbiote, pour un moment à l’écoute de ce qui fait notre multitude et nous rend bien vivant·es.« Et pourtant nous sommes une foule tremblanteDes corps qui grouillentPeuplés de bestioles qui habitent làNichées de toute partDes marées qui vont et viennentDe corps en corpsHistoires invisibles, ou presqueSuis-je un Nous ? »Dans le cadre de Pister l’invisible, une résidence d’artistes à Nantes Université imaginée par la Direction culture avec le Collectif de la Meute
Théâtre Francine Vasse Nantes 44000
Afficher la carte du lieu Théâtre Francine Vasse et trouvez le meilleur itinéraire